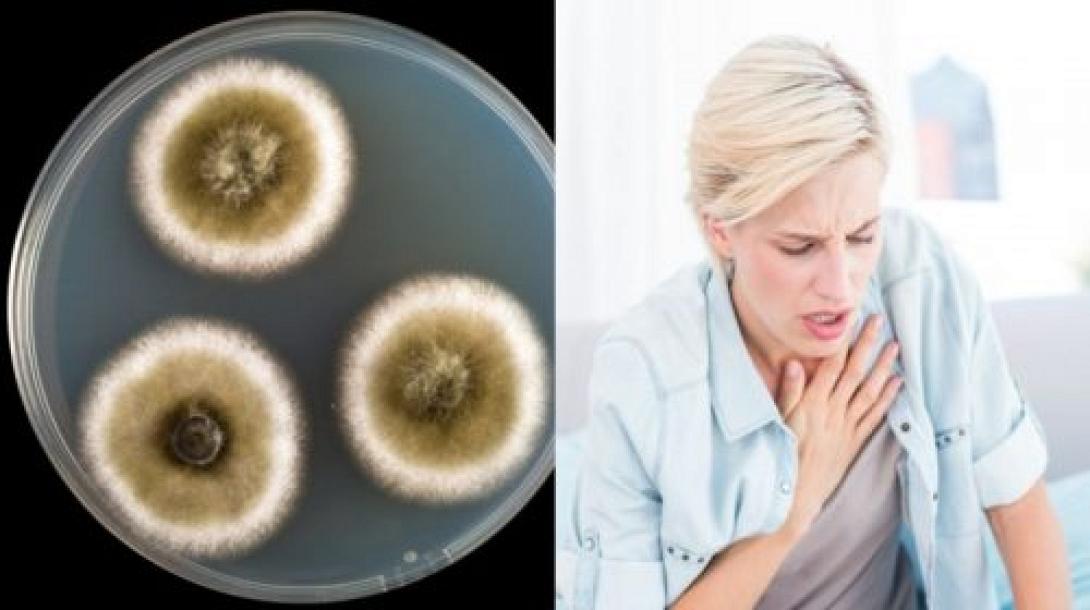
mouhla.jpg

Μήπως έχετε μούχλα στο σπίτι σας; Εάν ναι, θα πρέπει να γνωρίζετε ότι μπορεί να προκαλέσει βλάβες στην υγεία σας.
Η μούχλα ενδεχομένως να είναι ένας σιωπηλός και ύπουλος εχθρός που μπορεί να προκαλέσει κάθε είδους προβλήματα υγείας. Ωστόσο, μπορεί να ανησυχείτε όταν βλέπετε δείγματα μούχλας σε διάφορα μέρη του σπιτιού, χωρίς να σκέφτεστε όμως ότι μπορεί να είναι η αιτία περίεργων συμπτωμάτων.
Ενώ πολλά σπίτια κρύβουν πηγές μούχλας, συχνά δεν τα θεωρούμε και τόσο σημαντικό παράγοντα ανησυχίας μέχρι να γίνει ένας πραγματικός κίνδυνος για την υγεία μας. Ποιος μπορεί να σκεφτεί ότι αυτοί οι μικροσκοπικοί μύκητες που κρύβονται στο υγρό περιβάλλον του σπιτιού μας μπορεί να είναι ο λόγος πίσω από ασθένειες του ανώτερου αναπνευστικού ή και άλλων νοσημάτων;
Όταν μένετε σε ένα κτήριο που έχει υποστεί υδραυλικές βλάβες (WBD), χωρίς να το καταλαβαίνετε, εισπνέετε μικροσκοπικά μόρια μούχλας τα οποία οδηγούνται στους πνεύμονες και μπορούν να δημιουργήσουν φλεγμονή στον οργανισμό σας και να επιδεινώσουν το ανοσοποιητικό σας σύστημα προκαλώντας διάφορα προβλήματα.
Προσέξτε! Αυτό δεν πρέπει να το αντιμετωπίσετε σαν μια άλλη κοινή αλλεργία, αλλά σαν μια σοβαρή κατάσταση που μπορεί να έχει σοβαρές συνέπειες για την υγεία, εκτός εάν αντιμετωπιστεί σωστά με τον κατάλληλο τρόπο.
Μήπως πάσχετε από ασθένεια της μούχλας;
Μην ξεχνάτε ότι η μούχλα μπορεί να κρύβεται και ίσως να μην είναι ορατή στο σπίτι σας. Παρατηρήστε αυτά τα πέντε προειδοποιητικά σημάδια που μπορεί να δείχνουν ότι μπορεί να πάσχετε από ασθένεια της μούχλας και όχι από μια απλή αλλεργία.
Ανεξήγητοι μυϊκοί πόνοι.
Σίγουρα, αν εργάζεστε πολύ, ενδεχομένως να αντιμετωπίζετε πότε-πότε μυϊκούς πόνους. Ωστόσο, μυϊκοί πόνοι που δεν είναι αποτέλεσμα οποιασδήποτε δραστηριότητας είναι ένα από τα κύρια σημάδια της ασθένειας της μούχλας. Η ασθένεια αυτή μπορεί να οδηγήσει σε μυϊκές κράμπες, μυρμηγκιάσματα και πόνο που μπορεί να πλήξει οποιοδήποτε μέρος του σώματός σας.
Ομίχλη εγκεφάλου, προβλήματα μνήμης και δυσκολία συγκέντρωσης.
Ένα άλλο βασικό σύμπτωμα της ασθένειας της μούχλας είναι η ομίχλη του εγκεφάλου, τα προβλήματα μνήμης, η δυσκολία συγκέντρωσης, ο προβληματισμός για τον εαυτό σας και το αίσθημα ατονίας του εγκεφάλου. Οι συχνοί πονοκέφαλοι είναι άλλη μια ένδειξη, ειδικά αν δεν έχετε ιστορικό κεφαλαλγίας.
Μούδιασμα.
Το μούδιασμα σε συνδυασμό με μια αίσθηση «νιώθω να με διαπερνούν βελόνες σε όλο το σώμα» ή πόνου που μοιάζει με επαφή με παγωμένη επιφάνεια μπορεί να είναι ένα σύμπτωμα ασθένειας της μούχλας. Μπορεί να συνδυάζεται με μυϊκές κράμπες.
Πεπτικά προβλήματα.
Η ασθένεια της μούχλας δεν εκδηλώνεται μόνο στους μύες σας, αλλά μπορεί επίσης να προκαλέσει πεπτικές διαταραχές. Μπορεί να προκαλέσει ναυτία, πόνο στο στομάχι, διάρροια και απώλεια όρεξης.
Αναπνευστικά προβλήματα.
Τα αναπνευστικά προβλήματα είναι ένας από τους λόγους που πολλοί άνθρωποι μπερδεύουν την ασθένεια της μούχλας με αλλεργίες. Ωστόσο, η ασθένεια της μούχλας μπορεί να οδηγήσει σε σοβαρές αναπνευστικές επιπλοκές. Μπορεί να έχετε δυσκολία στην αναπνοή, ή να αδυνατείτε να πάρετε βαθιές εισπνοές. Ίσως έχετε συνεχή βήχα ή να εκδηλώσετε προβλήματα φλεβοκόμβου και συριγμό.
Εάν υποψιάζεστε ότι πάσχετε από την ασθένεια της μούχλας, επικοινωνήστε με τον γιατρό σας το συντομότερο δυνατό. Για να αποφύγετε μακροχρόνιες επιπλοκές της ασθένειας της μούχλας, είναι σημαντικό να βρείτε τρόπους θεραπείας.
Η αποκατάσταση και η αντιμετώπιση της ασθένειας περιλαμβάνει συνήθως διατροφή με τροφές ολικής άλεσης ή με τροφές με αντιφλεγμονώδεις ιδιότητες, τροφές με αντιμυκητιακές ιδιότητες, όπως τζίντζερ, σκόρδο και πιπέρι καγιέν, προβιοτικά και αντιμυκητιακά συμπληρώματα βοτάνων.
Κείμενο – Απόδοση, Λ.Τ.
naturalsoul.gr